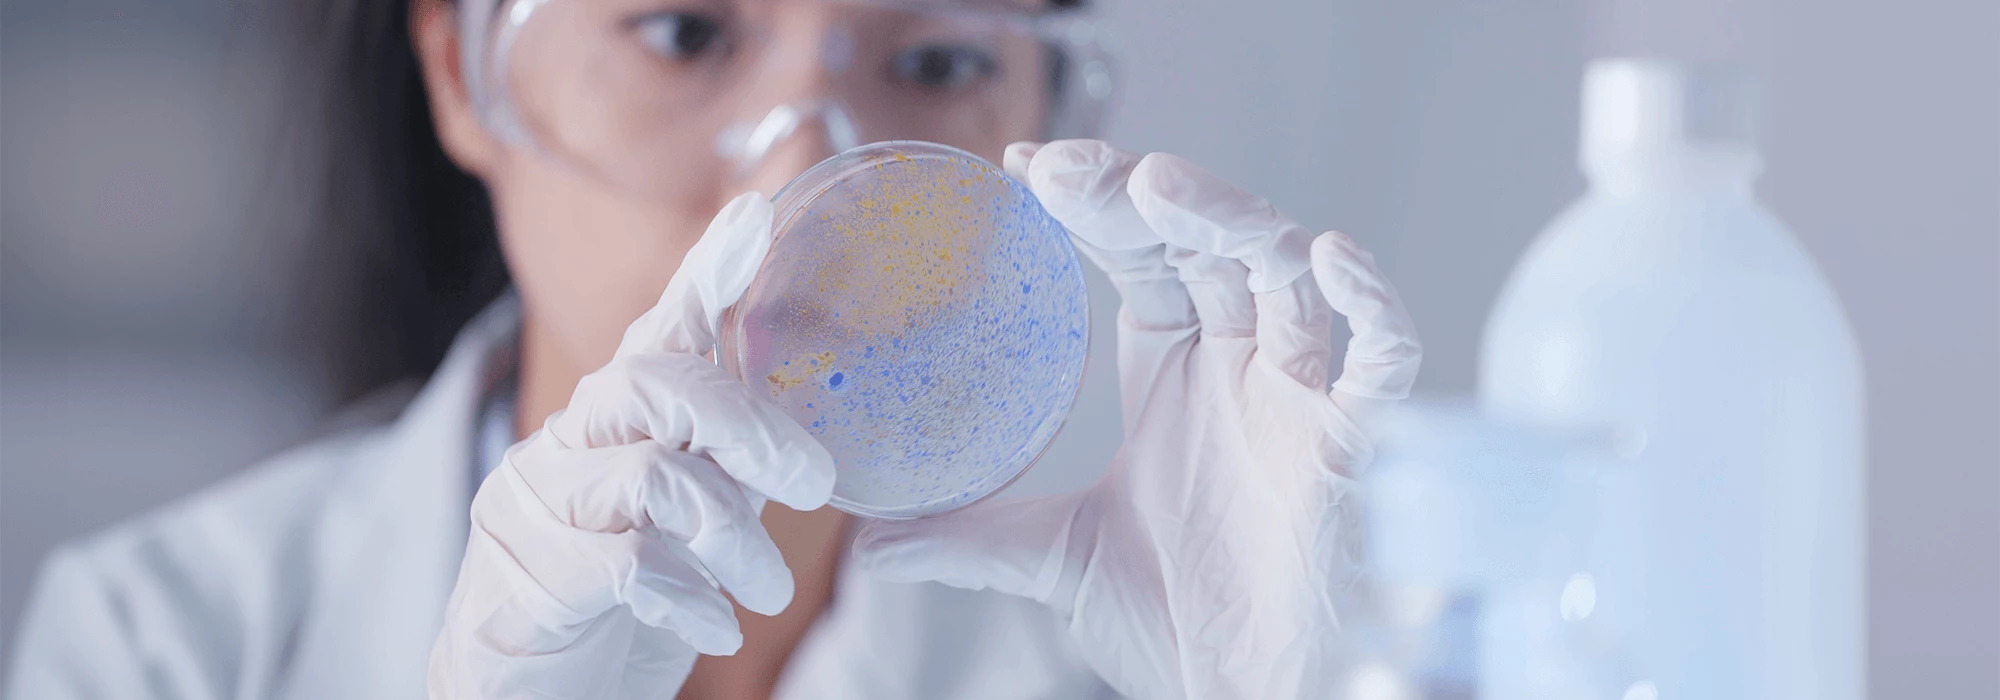

Connecting you with pathology experts.
When your case calls for precise medical expertise, we help you select the best-aligned option from our invitation-only expert panel and provide seamless case support to protect your time and deadlines.
Pathology can range from managing chronic illnesses to diagnosing malignant diseases. Pathologists work closely with surgeons, radiologists, and oncologists and use gross, microscopic, immunologic, genetic, and molecular modalities to determine the presence of disease. Pathology is critical to the research and advancement of medicine, including the treatment of infectious diseases and cancer.
Pathologists often choose to specialize further through fellowship training for one to two years, which provides advanced education and practical experience in specific areas of pathology, such as surgical pathology, cytopathology, hematopathology, neuropathology, or forensic pathology.
Pathology readings can include:
- Bone and soft tissue pathology
- Breast pathology
- Cardiovascular pathology
- Cytopathology
- Dermatopathology
- Gastrointestinal pathology
- Genitourinary pathology
- Gynecologic pathology
- Head and neck pathology
- Hematopathology
- Liver pathology
- Pulmonary pathology
- Renal pathology
- Transplant pathology
IMS has specialists in this area of clinical focus, each with the necessary knowledge, experience, and qualifications to serve as an expert witness in your personal injury or medical malpractice case.
Learn about our proven process and contact our team below.